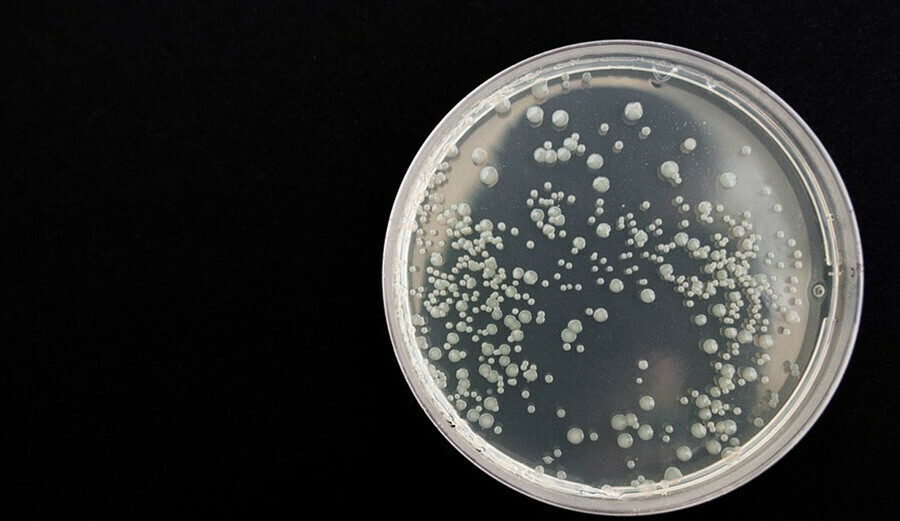

Yeni salgın sinyali! Milyonlarca kişiyi öldürebilir… DSÖ, 19 ölümcül türü açıkladı

Dünya Sağlık Örgütü, mantar salgınlarının insanlar için oluşturduğu riskin hızla arttığını söyledi. Uzmanlar sinir sistemine saldıran mantarların milyonlarca kişinin ölümüne yol açabileceğinin altını çizdi. Örgüt yeni yayımladığı raporda, 19 ölümcül tür olduğunu vurguladı.
Dünya Sağlık Örgütü, giderek yaygınlaşan, tedaviye dirençli ve ölümcül olmalarına rağmen büyük ölçüde göz ardı edilen patojenler grubuna dikkat çekmek için uyarıda bulundu. Örgüt, ilk kez halk sağlığı açısından tehdit olan mantarlardan oluşan 'öncelikli patojenler' listesini yayımladı.
DSÖ, her yıl beş milyon kişinin ölümüne neden olan ve “kritik bir öncelik” olarak tanımladığı en tehlikeli 19 mantar türünün yer aldığı listeyi paylaştı.
“GİDEREK YAYGIN HALE GELİYOR”
DSÖ hastalık gözetimi yetkilisi Dr. Carmem L. Pessoa-Silva, Salı günü yapılan toplantıda “İnvaziv mantar enfeksiyonları daha yaygın hale geliyor, ancak sıklıkla hastalarda tanınmıyor ve doğru şekilde tedavi edilmiyor” dedi.
Örgüt, yayımladıkları raporu bir eylem çağrısı olarak niteledi ve hükümetlerin, sağlık yetkililerinin bu duruma öncelik vermeleri gerektiğinin altını çizdi.
Koronavirüs pandemisinden bu yana uzmanlar, hastaneye kaldırılan hastalar arasında ölümcül mantar hastalıklarında bir artış olduğunu fark etti.
Raporda, kandida oral ve vajinal pamukçuk gibi yaygın enfeksiyonlara neden olan mantarların tedaviye karşı giderek daha dirençli hale geldiği belirtildi.
Uzmanlar, antibiyotiklere karşı giderek daha dirençli hale gelerek, mantarlardan kaynaklanan istilacı enfeksiyonların büyük bir risk haline gelebileceği konusunda sert bir uyarı yaptı.
Uzmanlar, antibiyotiklere karşı giderek daha dirençli hale gelerek, mantarlardan kaynaklanan istilacı enfeksiyonların büyük bir risk haline gelebileceği konusunda sert bir uyarı yaptı.
Dünya Sağlık Örgütü, izlenmesi gereken 19 mantar patojeni hakkındaki ilk raporunda, mantar önleyici direncin insan sağlığı için "önemli etkileri" olduğunu söyledi.
İŞTE EN TEHLİKELİ MANTAR TÜRÜ
Hangi mantarların en endişe verici olduğunu bulmak için 30 araştırmacıdan oluşan bir ekip, 6 bin bilimsel makaleyi analiz etti ve 400'den fazla uzmandan tavsiye istedi.
Uzmanlar, halk sağlığı üzerindeki etkilerine ve antifungal ilaçlara direnç riskine göre 19 mantarı kategorize etti.
Raporda, 19 mantardan dördü “kritik” önceliğe sahip olarak tanımlandı. Bunlar; Cryptococcus neoforman, Candida auris, Aspergillus fumigatus, Candida albicans olarak sıralandı.
- Candida auris, yüksek salgın potansiyeline sahip bir mayadır. Ölüm oranı yüzde 29 ile yüzde 53 arasında değişir ve mevcut mantar önleyici ilaçların çoğuna dirençlidir.
- Aspergillus fumigatus, toprakta bulunan ve esas olarak akciğerleri etkileyen ve bazı durumlarda beyne de bulaşabilen kritik önceliğe sahip bir başka mantardır.
- Cyptococcus neoformans, çoğunlukla toprakta veya çürüyen ahşapta bulunan bir başka "kritik" mantardır. Başlangıçta akciğerleri etkiler ancak beyne yayılarak ölüme ve ciddi sakatlığa neden olabilir. HIV'li olanlar için ölüm oranı yüzde 41 ila 61'dir.
- Kritik risk kategorisindeki son patojen, genellikle hastanelerde bulunan ve ilaçlanması veya temizlenmesi zor olabilen candida albicans olarak isimlendirilir. Çoğu durumda kolayca tedavi edilebilir ve uzun süreli sağlık sorunlarına neden olmaz.
Kaynak: The Sun







